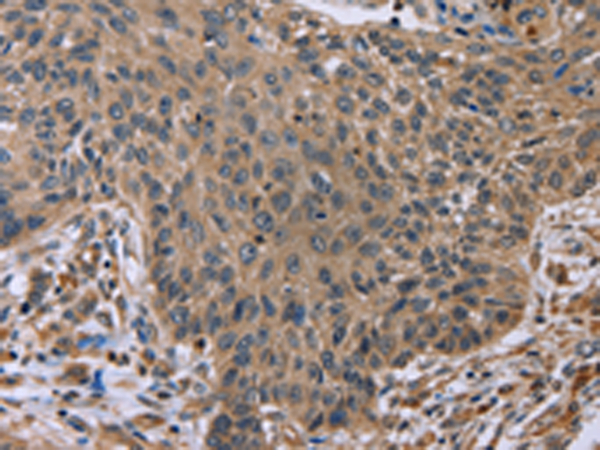

|
Background: |
The protein encoded by this gene is a type II membrane protein that can be cleaved by furin to produce a secreted form. The encoded protein, which belongs to the tumor necrosis factor family, acts as a homotrimer and may be involved in cell-cell signaling during the development of ectodermal organs. Defects in this gene are a cause of ectodermal dysplasia, anhidrotic, which is also known as X-linked hypohidrotic ectodermal dysplasia. Several transcript variants encoding many different isoforms have been found for this gene. |
|
Applications: |
ELISA, IHC |
|
Name of antibody: |
EDA |
|
Immunogen: |
Fusion protein of human EDA |
|
Full name: |
ectodysplasin A |
|
Synonyms: |
ED1; HED; EDA1; EDA2; HED1; ODT1; XHED; ECTD1; XLHED; ED1-A1; ED1-A2; EDA-A1; EDA-A2; STHAGX1 |
|
SwissProt: |
Q92838 |
|
ELISA Recommended dilution: |
2000-5000 |
|
IHC positive control: |
Human lung cancer |
|
IHC Recommend dilution: |
50-200 |
購物車
購物車 幫助
幫助
 021-54845833/15800441009
021-54845833/15800441009
